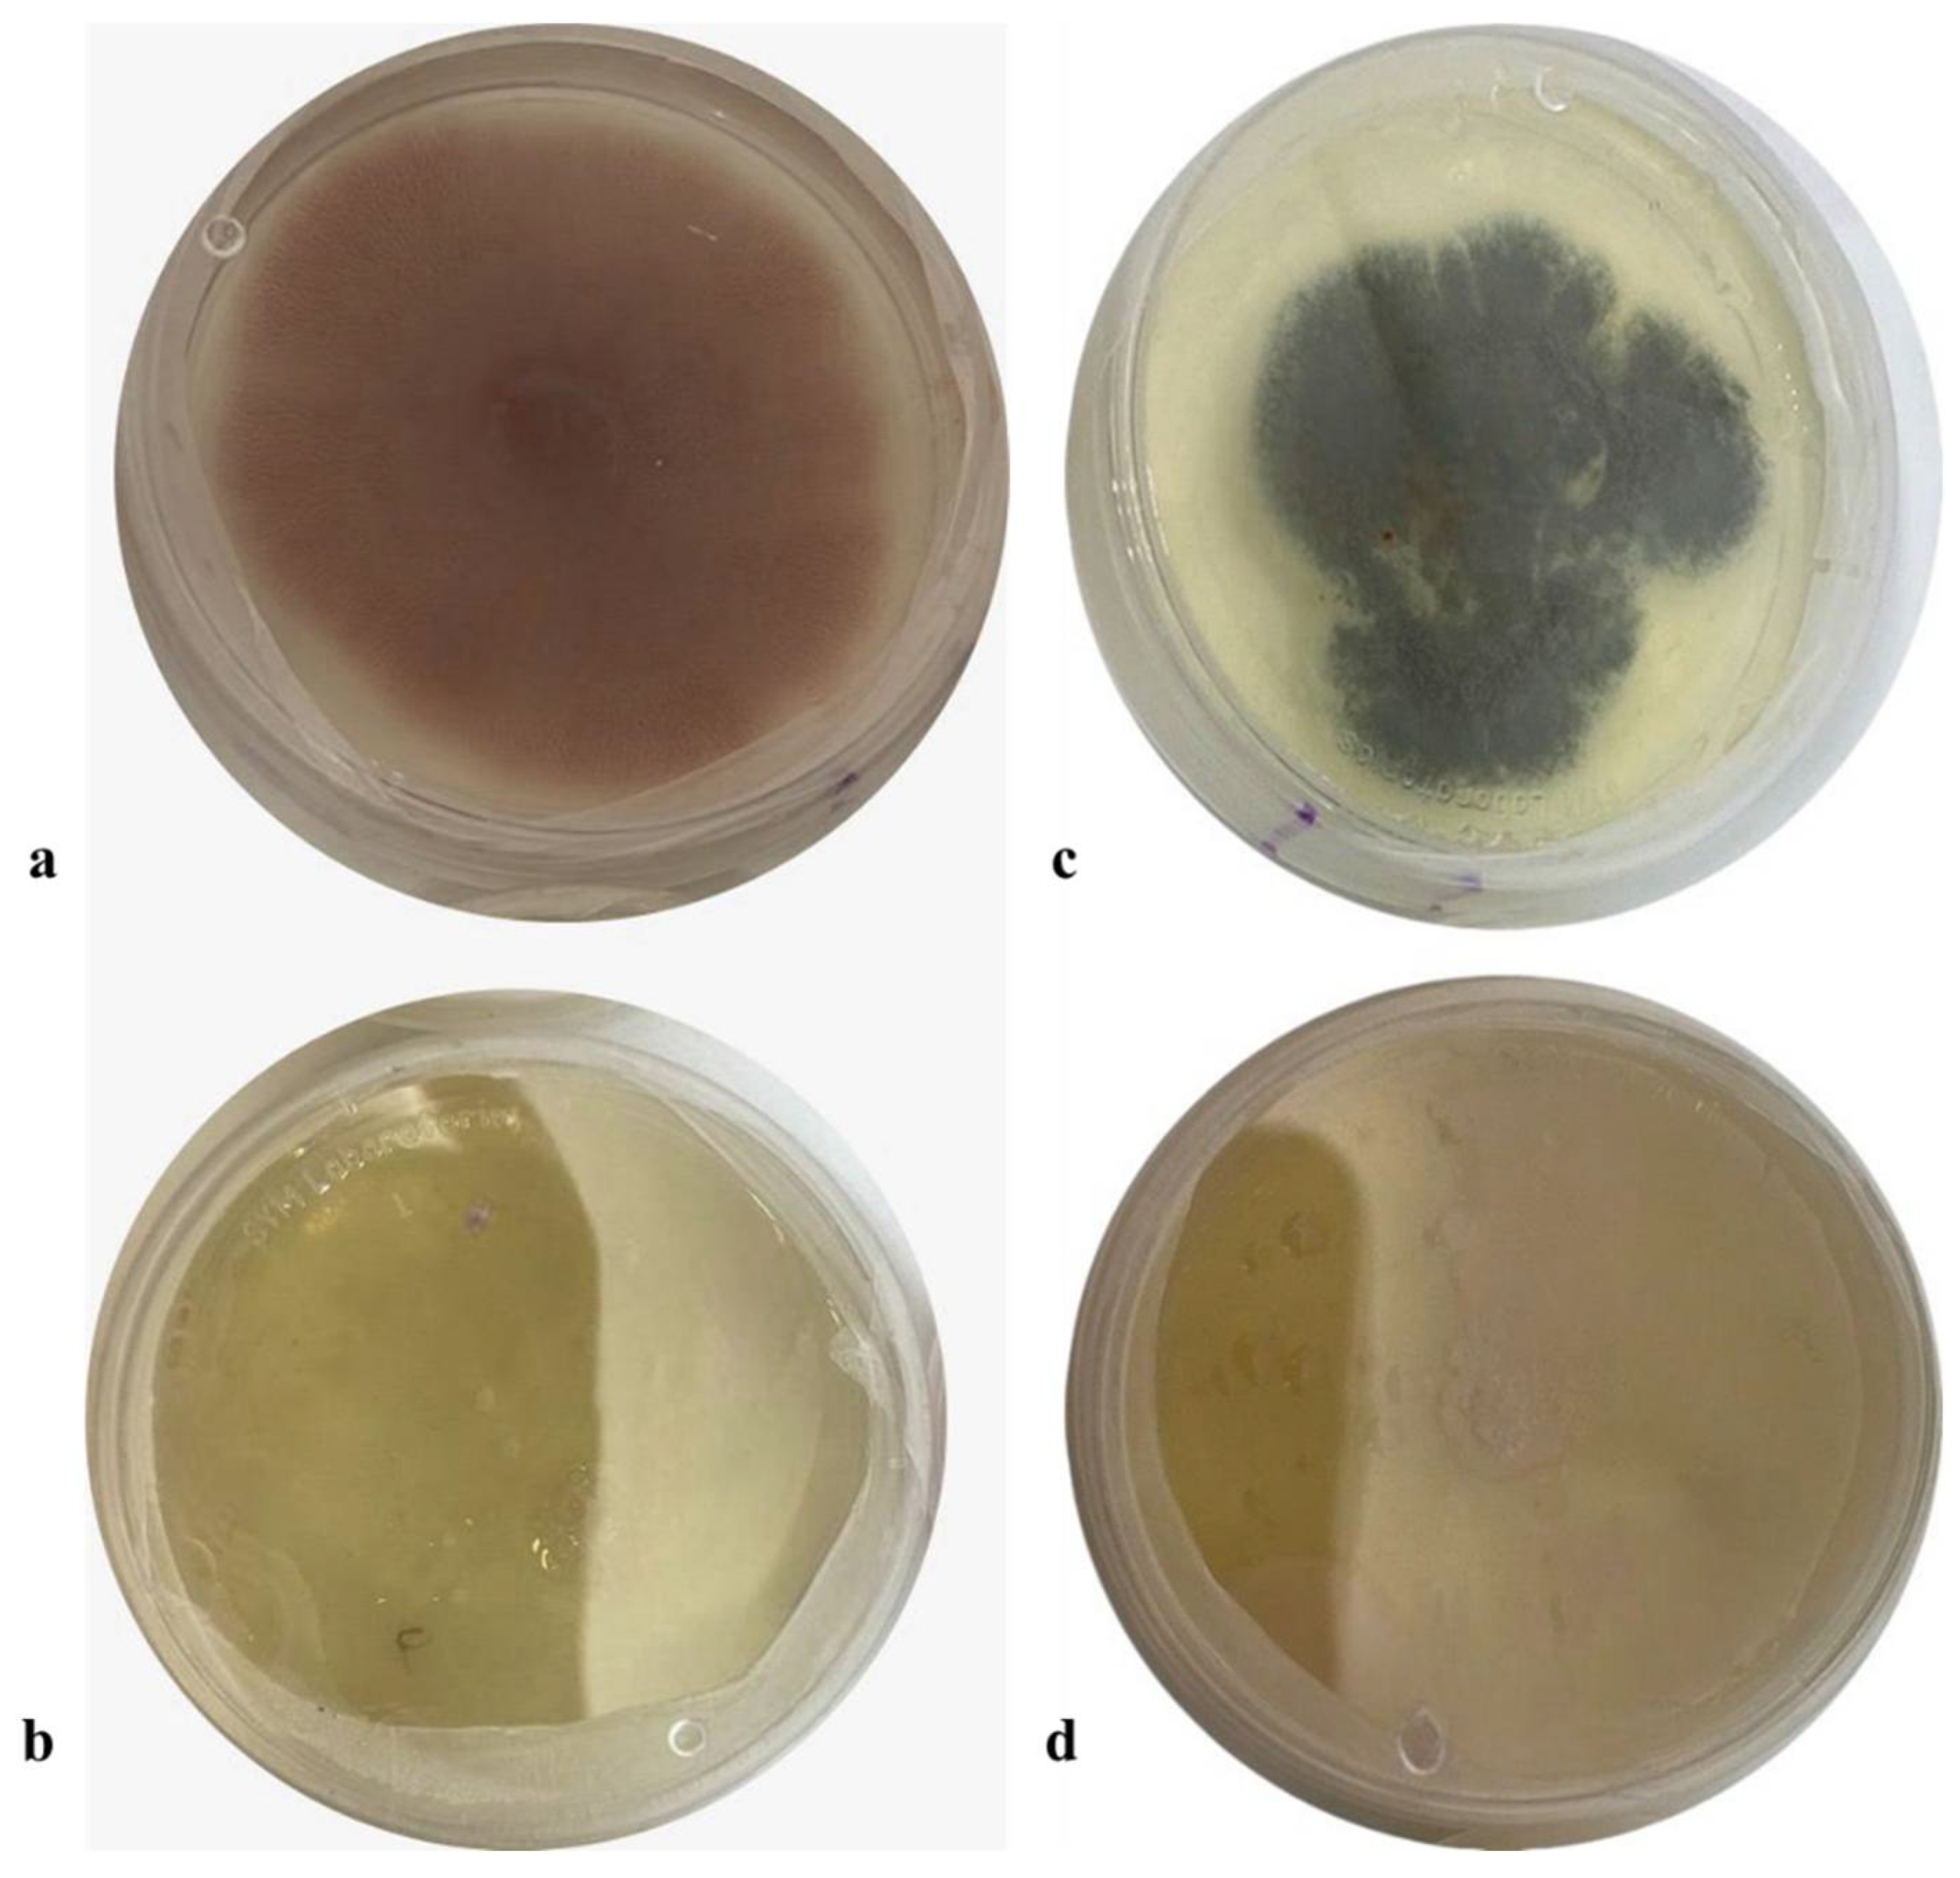
Processes 13 02064 g008

Abstract
Biopesticides represent a safe and sustainable strategy for biological pest management, applicable to weed and fungal control. Biotechnological processing offers a promising approach to enhance the bioactivity of natural products for agricultural use. In this study, guishe juice, an agroindustrial residue derived from Agave lechuguilla, was bioprocessed via inoculation with Fusarium chlamydosporum, and its fungicidal and herbicidal potentials were evaluated. The fungal biotransformation led to the accumulation of phytochemicals, including flavonoids and polyphenols, significantly enhancing antioxidant activity to 76% and 96% as measured by DPPH and ABTS assays, respectively. The resulting bioprocessed guishe extract (BGE), particularly at 10% concentration (BGE-10), exhibited strong fungicidal activity, achieving 100% control of phytopathogenic fungi Fusarium spp. and Penicillium spp. Additionally, BGE-10 demonstrated a bioherbicidal effect, with a 77% weed control rate against Verbesina encelioides. These findings emphasize the potential of bioprocessed agave residues as dual-action bioagents, supporting the development of novel, eco-friendly agricultural solutions.
1. Introduction
Nature provides a large number of molecular compounds with important biological functions for the food, pharmaceutical, and agricultural industries; however, the main challenge is to access these compounds and increase the libraries of molecular structures to improve the quality of life [1]. One of the current strategies to increase the number of compounds with benefits for different industries is the study of the microbial ecology associated with plants [2]. This strategy has gained importance because it has a high potential, mainly due to the symbiotic relationship that exists both for the assimilation and incorporation of nutrients into the soil, which helps the plant, as well as the resources that the microorganisms take from the plant for their development [3]. All these microbial processes can be studied to evaluate their biotechnological potential to transform plant material and produce other types of compounds of interest in the agrofood industry [4]. The Agave genus comprises several species that are geographically distributed in tropical and subtropical regions of the world, and it has adapted to arid and semiarid climates in various regions of the world, mainly in the semidesert regions of Mexico, and its importance is noted in different varieties [5]. The adaptation of these Agave species to semidesert conditions and their capacity to produce different metabolites make them the object of research and their use [6]. Among these species is Agave lechuguilla Torr, which is a non-timber forest resource native to North America. In Mexico, it can be found mainly in the southeastern states of Coahuila, parts of Chihuahua and Zacatecas, Nuevo Leon, Durango, Tamaulipas, and San Luis Potosí, covering approximately 20 million hectares [7]. In recent works, a general description of the metabolism of these compounds has been identified in A. lechuguilla by transcriptomic profiling, where the predominant synthesis of kaempferol, quercetin, isorhamnetin, myricetin, glycosides, rutinosides, anthocyanins, and isoflavones, among other compounds, has been identified, which have high value for different industries. The expression of these genes has been confirmed by quantifying these compounds by HPLC-DAD, which confirms that the transcriptome analysis can be a reliable alternative for the bioprospecting of metabolites [8]. Some studies have been conducted to determine the types of endophytic microorganisms of certain plants, which can have biotechnological importance in Agave, including different microorganisms, especially fungi, such as Fusarium chlamydosporum, which has been isolated from Agave species [9,10,11,12,13]. Microorganisms have been studied for their capacity to produce enzymes capable of degrading lignocellulose polymers into biomass, and belong to the group of cellulolytic enzymes, including laccases, peroxidases, endoglucanases, exoglucanases, β-glucosidases, β-xylosidases, and feruloyl esterases [14,15]. Filamentous fungi, such as Aspergillus niger or Trichoderma viridae, are adept at producing hydrolytic enzymes that can contribute to the depolymerization of cellulose, its derivatives, and certain glycosides [10,16]. Filamentous fungi have also been reported to contribute to increasing bioactivities from partially degraded plant material to release and improve bioavailability of high-added-value compounds [17], such as Fusarium chlamydosporum isolated from guishe from Agave lechuguilla, and it has been used in preliminary studies by bioprocessing guishe extract and allelopathic assays in model seeds [10]. Regarding F. chlamydosporum role in biotechnological approaches, it has been used as a source of lignocellulolytic enzymes and bioactive secondary-metabolism compounds [11,12,13]. Phytochemicals are molecules naturally present in the plant kingdom and are a part of their secondary metabolism in “non-essential” biological actions, which intervene in the interactions between the plant and its environment [18]. These are protective interactions in periods of stress, helping the plant to adapt and survive natural aggressors, as there are between 5000–10,000 types of phytochemicals, and for the last few decades they have been researched and identified. To date, more than 900 phytochemicals have been identified, and the action of a few has been studied in depth [19,20]. Some of the applications of these phytochemicals are as environmental protectors (UV radiation, desiccation, stress), protection against viruses, fungi, bacteria, and parasites, protection against stress, as well as antioxidants [8,21,22,23]. These bioactive compounds act as allelochemicals to affect growth, which is the case in weed control, as they disrupt metabolic processes to hinder stem formation or chlorophyll accumulation, and in turn, compromise the viability of the plant. Also, this type of bioactive compounds possesses activities that hinder or inhibit fungal growth by affecting its cellular processes [10,24] Thanks to this knowledge, organic production models have been developed in recent years using these phytochemicals and applying them to crops of agricultural importance to control different diseases and boost agricultural production [25]. The indiscriminate use of chemical fungicides for disease control has led to the development of resistance in phytopathogens, contaminating the atmosphere and affecting human health through the presence of residual toxic compounds in food for human consumption [22]. The use of biopesticides for pest control is an option that, by their nature, can be used safely in sustainable agriculture, and an example of this is the use of botanical products, which are less expensive, with bioactive compounds that are biodegradable and safe for humans and the environment [26]. Considering the fact that guishe extract contain bioactive molecules and that bioprocessing may improve its effects, the objective of this work is to carry out biotechnological processing through the use of endophytic fungi to accumulate and increase the availability of bioactive compounds from the guishe extract of A. lechuguilla, thus increasing the biological activity of the plant material in regard of antioxidant activity and weed and phytopathogenic fungal control as potential agricultural applications.
2. Materials and Methods
2.1. Biological Material
Fusarium chlamydosporum (Access number: PV010374, NCBI) was isolated from A. lechuguilla collected in Cosme, Ramos Arizpe, Coahuila, Mexico. The guishe extract for the experiments was obtained by mechanically pressing A. lechuguilla residue, also acquired from the community of Cosme, Ramos Arizpe, Coahuila, Mexico (Figure 1). Phytopathogenic strains of Fusarium spp. and Penicillium spp. were provided by the Agricultural Microbiology and Biotechnology Laboratory of the School of Chemical Sciences. UAdeC. Weed seeds of the species Verbesina encelioides (Access number: HCIB32365) were collected in the municipality of General Cepeda, Coahuila, and deposited in the herbal collection of the Northwest Biological Research Center (CIBNOR).
Figure 1.
Guishe extract recovery process from byproduct accumulation from Agave lechuguilla ixtle, mechanical pressing, and flask placement before fermentative procedure.
2.2. Bioprocessing of Guishe Extract
The biomass was obtained, according to Schumann et al. [27], by inoculating Sabouraud broth (Difco, Mexico) and guishe extract 1:1 with a nylon membrane (300 mesh) with the immobilized growth of Fusarium chlamydosporum previously incubated for 7 days (Figure 1). Each flask was placed on this mesh with F. chlamydosporum mycelium and incubated at 30 °C for 120 h, sampling every 24 h. The composition of the guishe juice was: (g/L) 10.88 of sugars, 3.43 of hydrolysable polyphenols, and 11.68 of flavonoids; pH level of 5.56. The experiment was performed in triplicate.
2.3. Biotransformed Extracts Recovery and Sample Analysis
Bioprocessed guishe extract (BGE) sampling was carried out by removing the nylon membrane used from each of the sacrificed flasks of each time with sterile tweezers and placing it in a sterile Petri dish, the liquid part was placed in a centrifuge tube and centrifuged at 6000 rpm for 30 min, the supernatant was recovered and filtered through a 0.45 µm membrane. All samples were analyzed for sugar content using an Agilent 1260 Infinity High Performance Liquid Chromatograph with an Agilent Hi-Plex H column (35 °C) and 5 mM H2SO4 (Sigma-Aldrich, St. Louis, MI, USA) as the mobile phase at a flow rate of 0.5 mL/min and a refractive index detector at 45 °C.
2.4. Spectrophotometric Analysis
Total sugars, hydrolyzable polyphenols using gallic acid (Sigma-Aldrich, USA) as a standard, flavonoids using quercetin (Sigma-Aldrich, USA) as a standard, and antioxidant activity by DPPH (Sigma-Aldrich, USA) and ABTS (Sigma-Aldrich, USA) techniques were measured using a spectrophotometer (Varian, Cary 50 UV-Visible, Santa Clara, CA, USA) [8,22,28].
2.5. Bioassays
For the bioactive assays, the fermentation time with the highest concentration of bioactive compounds was selected from guishe bioprocessing for subsequent experiments. Based on this, the BGE was evaluated at concentrations of 0.5, 1, 10, and 100%, which were coded as BGE-0.5, BGE-1, BGE-10, and BGE-100, respectively, for the antifungal and allelopathic assays.
2.5.1. Inhibition Assay on Phytopathogenic Fungi
Penicillium spp. and Fusarium spp. were grown on PDA supplemented with 0.5%, 1%, and 10% of the extract previously filtered through a 0.45 µm membrane. PDA without BGE was used as a blank control, and BGE-100 was not evaluated due to the lack of solidification of the PDA. The BGE-supplemented media were stored at 4 °C in a refrigerator for 24 h to allow complete homogenization of the components before inoculation. Inoculation was carried out by placing a 3 mm diameter and 3 mm height (approximately) square obtained from the active growth zones of the phytopathogenic fungal cultures in the center of a Petri dish (60 mm × 15 mm). The Petri dishes were incubated at 28 ± 2 °C for 144 h. After incubation, mycelial growth was determined by measuring the colony size to determine the percentage of growth compared to the control treatment and the percentage of inhibition according to Equation (1). Consequently, because it was assumed that the control had a mycelial growth of 100% (no inhibition), this value was not included in the tables of results. The experiment was performed in triplicate.
2.5.2. Allelopathic Assay on Verbesina encelioides Seeds by BGE
The experiment was carried out in three replicates per treatment, with each replicate consisting of 12 plants of Verbesina encelioides. Plant growth trays were prepared using a substrate mixture composed of 30% peat moss, 30% coconut fiber, and 40% compost. Subsequently, two to three seeds were sown in each well of each tray. All trays were irrigated daily with water using a sprinkler system for 45 days until seedlings with true leaves were obtained. Once the initial parameters were determined, 8 mL of each treatment was foliar-sprayed to each replica based on the volume applied by a spray system that delivered 200 L/ha, equivalent to 8 mL per plant. The evaluation was carried out 7 days after the application and the treatments were water as a negative control, glyphosate (Faena, Mexico) (4 mL/L), and BGE at 0.5, 1, 10, and 100%, respectively; each bioprototype was coded as BGE-0.5, BGE-1, BGE-10, and BGE-100. Subsequently, the effects of the treatments on the seedlings were evaluated and compared to those of a control group treated with water. The qualitative and quantitative aspects of the application of the bioprocessed extract were evaluated. Qualitative damage to the plant was observed through visual assessment according to the ALAM scale [29], as defined in Table 1.
Table 1.
Evaluation scale for plant damage due to herbicide effects.
For quantitative methods, the density, biomass, and height of the plants of the species evaluated were measured. Fresh biomass was determined at the end of the assay by cutting the weeds present in the entire area corresponding to each repetition of each treatment at the substrate level (aerial biomass) and weighing them on a balance. The number of weeds per replicate was measured to estimate density. Once these parameters were determined, they were used to calculate weed control efficiency (WCE) considering the effects on biomass (WCE-B), density (WCE-D), height (WCE-A), and damage (WCE-d) of each of the treatments using the procedure used by Lopez-Urquídez et al. [29] from their proposed equations to calculate it based on biomass generation (Equation (1)).
where %WCE B = Percentage of Weed Control Efficiency as a function of Biomass; Bc = Biomass of the control; and Bt = Biomass of the treatment.
The WCE-B for each treatment was calculated using Equation (2).
where %WCE D = Percentage of Weed Control Efficiency as a function of Density; Dc = Control density; and Dt = Treatment density.
The WCE-D of each treatment was also calculated from the following equation (Equation (3)).
where % WCE A = Percentage of Weed Control Efficiency as a function of final height, Ac = Control height, and At = Treatment height.
We also calculated the WCE-A for each treatment compared to the control using the following equation (Equation (4)).
where % WCE d = Percentage of Weed Control Efficiency as a function of damage; dc = control damage; and dt = treatment damage.
Each of these parameters was averaged for each treatment to calculate the final Weed Control Efficiency. Considering these four parameters and using the Latin American Weed Association—ALAM scale, the weed control index (WCI) was determined, and the classification of each treatment according to the degree of control was performed according to the scale described in Table 2.
Table 2.
Weed control index and classification according to the Latin American Weed Association (ALAM) scale.
2.6. Statistical Analysis
Data were analyzed using Minitab® 20.3. Tukey’s mean comparison test was performed at 95% confidence. All experiments were performed in triplicate.
3. Results and Discussion
3.1. Bioprocess of Guishe Extract
During the bioprocessing of the guishe extract evaluated in this experiment, nylon membrane biomass immobilization was effective in obtaining fungal mycelium more easily than cultures in liquid medium. In 100% guishe extract (BGE-100), 3.3 g of biomass (fresh weight) was obtained at 72 h, and at 120 h, 11.63 g (fresh weight) of biomass was obtained. This inoculation method provided additional information on the removal of fungal biomass, which has some advantages over traditional liquid methods for obtaining mycelium, as fungi produce asexual structures, such as spores. However, using mycelia to obtain high-quality nucleic acids is preferable [27]. The amount of biomass described above is consistent with the behavior of the substrate during the fermentation process, which decreased with the incubation time. The process started with a sugar concentration of 10.88 g/L. A decrease of more than 50% in sugar content was observed during the first 24 h of the process (4.66 g/L), gradually decreasing until a concentration of 0.11 g/L of sugars at 120 h (Figure 2).
Figure 2.
Sugar content in bioprocessed guishe extract was determined by HPLC. Different letters indicate differences according to statistical analysis.
For sugar quantification along the bioprocesses, the results obtained by HPLC and spectrophotometry are shown in Figure 2 and Figure 3, respectively. The total sugar content decreased from a concentration of 9.89 g/L, and then a decrease was observed at 24 h, reaching a concentration of 7.8 g/L, then at 48 h 5.97 g/L, at 72 h 6.11 g/L and 6.25 g/L at 96 h showing a stationary phase and then a total decrease to 0.99 g/L.
Figure 3.
Monomeric sugar content in BGE quantified using a spectrophotometric method. Different letters indicate differences according to statistical analysis.
The Fusarium chlamydosporum strain accumulated both flavonoids and phenolic acids, as it accumulated 29.22 g/L of flavonoids and 1.20 g/L of total hydrolyzable polyphenols at 72 h of incubation, as shown in Figure 4 and Figure 5. This accumulation of compounds is related to the biodegradation of the molecules present in the guishe extract; for instance, phenolic compounds can be found in nature in the form of glycosides; therefore, it is possible that the fungus has the ability to biotransform these compounds, increasing the diversity of the bioactive molecules [24].
Figure 4.
Flavonoid content (quercetin equivalents) in BGE of Fusarium chlamydosporum. Different letters indicate differences according to statistical analysis.
Figure 5.
Hydrolyzable phenolic (gallic acid equivalent) content in BGE by Fusarium chlamydosporum. Different letters indicate differences according to statistical analysis.
These modifications made by microorganisms have resulted in better pharmacokinetic properties, new mechanisms of action, and fewer side effects in molecules of pharmaceutical applications. In a previous work [10], it was observed that compounds such as flavonoids and phenolic acids tend to accumulate during fermentation, resulting in 15 g/L of flavonoids, whereas in this study, approximately 30 g/L were quantified. The phenolic acid content in this current work was slightly lower than that in the previously mentioned work, and considering that both types of molecules, the bioactivities remain detectable and demonstrable in allelopathic assays [10]. According to previous work, flavonoids have been reported in Agave lechuguilla solid residues, such as apigenin, delphinidin, kaempferol, quercetin and their derivates [8] and in liquid extract of guishe, catechins, hydroxycinnamic acids and methoxyflavones were detected and those molecules being (+)-gallocatechin, hydroxycaffeic acid, dimethyl quercetin, coumaric acid and their derivates as well [10].
3.2. Antioxidant Activity
The antioxidant capacity of each extract was determined, showing that the extracts obtained from the fermentation of the Fusarium chlamydosporum strain in 100% guishe extract medium in a 1:10 dilution had high percentages of inhibition, as shown in Figure 6 and Figure 7. The ABTS assay showed that the extract at zero hours has a percentage inihibition of 67.24%, at 24 h it has an inhibition percentage of 68.55%, at 48 h it has a percentage inhibitiob of 74.56%, at 72 h it has a percentage inhibition of 96.37% at 96 h, the percentage inhibition decreased to 93.03% to finish at 120 h of incubation at 93.15%. The antioxidant capacity determined by DPPH assay showed an increase in radical inhibition, with the highest activity of 76.01% at 72 h of fermentation. The incubation time corresponding to 72 h in 100% guishe extract resulted in the accumulation of flavonoids and polyphenols, as well as the best percentage of free radical inhibition, expressing the best antioxidant capacity.
Figure 6.
ABTS antioxidant assay of the guishe extract bioprocessed by F. chlamydosporum. Different letters indicate differences according to statistical analysis.
Figure 7.
DPPH antioxidant assay of the guishe extract bioprocessed by F. chlamydosporum. Different letters indicate differences according to statistical analysis.
Agave lechuguilla has been used as a source of bioactive molecules that can be considered antioxidants [8,30], which can be correlated to the functionality of these extracts in different agricultural applications and their antioxidant capacity. These aspects may also be associated with the accumulation of phenolic compounds and flavonoids during fermentation [31]. Bioprocessing or biotransformation can improve antioxidant activity, which translates to bioavailability from low to high, considering that bioactive molecules are modified, improving the results in bioassays [32].
3.3. Evaluation of Bioprocessed Guishe Extract as a Fungicide
The extract obtained from the accumulation time was evaluated at different concentrations (10%, 1%, and 0.5% of bioprocessed extract (BGE)) on the growth of phytopathogenic fungi. All treatments showed significant differences compared to the control treatment. The concentration of BGE at 10% of the extract controlled 88% (±0.02) of Penicillum spp. and 100% (±0.07) of Fusarium spp. at 144 h of incubation (Figure 8).
Figure 8.
Effect of BGE-added PDA on fungal inhibition growth assay of Penicillium sp. and Fusarium sp. (a) Control of Fusarium sp. (b) BGE-10 (c) Control of Penicillium sp. (d) BGE-10.
Table 3 shows the inhibition percentages of each dilution evaluated compared to the control, which was not reported since it is known to be 100% inhibition. Agave lechuguilla extracts have been used for antifungal activities against several fungal strains, including Penicillium sp., with promising results, and the bioactivity is attributed to the phytochemical composition, which includes phenolic compounds [33]. Regarding phytochemicals, specifically hydrolyzable phenolics and flavonoids, a previous work reported the presence of bioactive compounds in BGE [10]. The evaluation of extracts at different concentrations to assess the percentage related to the accumulation of flavonoids and polyphenols described above in the time being evaluated in this study can be compared with reports identifying different flavonoids, such as catechins, methoxyflavones, isoflavones, furanocoumarins, and stilbenes, which have shown antibacterial, antiviral, and antifungal properties [8,10,22,23].
Table 3.
Inhibitory effect on Penicillium and Fusarium spp.
This biological activity is also related to high antioxidant capacity, as the activity of these biotransformed compounds can be very diverse, including antimicrobial, specifically antifungal, and other bioactivities such as antitumor, anti-inflammatory, anti-HIV, hepatoprotective, cardioprotective, analgesic, and other functions [24]. Phenolic molecules have been reported to be effective against mycotoxin-producing fungi, such as patulin, produced by Penicillium expansum, which has negative effects on human health, for which polyphenols are molecules with applications in fungicides or natural product development [34]. Other genera of plants found in the Mexican Semidesert, such as Rosmarinus, Larrea, and Flourensia, have been reported to be effective against fungi, with favorable results against fungal strains of agricultural interest, such as Penicillium and Fusarium strains [35,36,37].
3.4. Allelopathic Activity on Verbesina Encelioides Plants In Vivo
In the evaluation of the effect of the different concentrations of bioprocessed extract on the growth of Verbesina encelioides (Figure 9), it was observed that the treatments applied had a degree of control in the development of these weeds, as they showed significant differences, as shown in Table 4. From the results observed in the treatment EWC B, glyphosate as a control had a 75.58% effect on the biomass, which was similar to that of BGE-10 with a value of 75.54%. For BGE-1, the effect was 54.83% and 59.67% in BGE-100, respectively. The highest result in this instance was BGE-10, with an effect value of 81.32%. For the EWC D treatment, glyphosate had the most notable effect on density, with a value of BGE-100 WITH 85%, followed by BGE-10 with 80.95%, BGE-10 with 76.19%, BGE-1 with 23.81%, and BGE-0.5 with 19.05%. The effect on the height (EWC A) of Verbesina encelioides was 100% by glyphosate, BGE-100 had 74.68%, BGE-10 70.46%, BGE-0.5 16.29% and 3.7% by BGE-0.5.
Figure 9.
Visualization of the damage caused by bioprocessed juice (BGE) application. (a) Control, (b) Glyphosate, (c) BGE-0.5, (d) BGE-1, (e) BGE-10, and (f) BGE-100.
Table 4.
Allelopathic effect of Verbesina encelioides plants using several doses of the BGE together with positive (glyphosate) and negative (water) controls.
Glyphosate also had a 100% effect on the damage caused to the weed plants (EWC d). The highest effect in this regard was observed by BGE-10, showing no difference compared to BGE-100, with 87.5% and 85%, respectively; BGE-1 and BGE-0.5 had an effect of 72.44% and 76.25%, also with no statistical difference between them. The results of each of the WCE assays indicate that the parameters of biomass, density, height, and damage suggest that the BGE-10 and BGE-100 treatments have a herbicidal effect on the evaluated plant with a classification of Good according to the ALAM scale, with the BGE-10 having a weed control index of 77%, while the BGE-100 has a weed control index of 75% efficiency for the control of Verbesina encelioides.
Glyphosate was an excellent controller of plant development, confirming it as a chemical herbicide for weed control, as suggested on the product label. The biotransformation of guishe extract may be considered as an alternative to glyphosate substitution. The reductions in seedling growth and the damage caused by the application of the biotransformed extract could be attributed to the presence and accumulation of phenolic molecules, which, according to reports, can suppress protein and nucleic acid synthesis and inactivate several enzymes in growing plants [10,38]. Other reports attribute the allelopathic effect of plant extracts, such as guishe extract used in this study, to phenolic compounds isolated from its leaves, such as monoterpenoids, sesquiterpenoids, and bioactive phenolics such as gallic acid, quercetin, rutin, epicatechin, and ellagic acid [39,40]. According to the amount of phenolic compounds accumulated in the biotransformation process of the BGE extract of A. lechuguilla, these compounds may be responsible for the bioherbicidal activity, causing important damage in the plants of Verbesina encelioides. The mechanism of action of the bioprocessed extract (BGE) could be assumed to have a systemic and contact behavior since there is scientific evidence [41,42,43,44] that allows assuring that the phytochemicals present in the extract can increase the permeability of the membrane, which will modify the metabolism of the plant and will affect the development, inhibiting cell division and ending with the death of the plants, thus achieving an efficient control of weeds [45,46,47].
Other bioprocessing materials have been used for bioherbicide production. Cavalcante et al. [48] report that by bioprocessing orange peel and shrimp with fungal strains such as Trichoderma and Rhizopus, model seeds control was achieved with Cucumis sativus. Diaporthe sp. has been used for bioprocessing corn steep liquor with soybean bran, and its extracts have been used on Curcumis sativus seeds for potential bioherbicidal activity, where foliar damage was observed [49]. In addition, Schein et al. [50] mentioned that strains of Aspergillus flavus, Nigrospora sphaerica, and Bacillus velezensis have shown promise against weeds such as Amaranthus sp., Conyza sp., Echinochloa, and Bidens sp. from microbial cultures and ultrasound-assisted extraction from a liquid growth medium.
From a commercial standpoint, the main competition for any new product would be glyphosate, glufosinate-ammonium, and paraquat, which are widely available and highly effective. Our work is a fraction of a larger effort to produce bioherbicide options with promising results, which are yet to be published and are still being analyzed for their potential impact in the market. In terms of costs, on average, the herbicidal synthetic products cost 23 dollars [51]. The already available products have a relatively simple marketing process considering the demand by producers, while new products have to invest in transportation, marketing, and other aspects with the goal of market establishment, which is a challenge that has to be overcome, but is worthy of the effort. The prototype mentioned in this work has the potential to be an innocuous alternative to common herbicidal products, without the effects on human health, and the process would not be economically demanding.
4. Conclusions
Bioprocessed guishe had a positive effect on the control and management of phytopathogenic fungal strains and the weed Verbesina encellioides, which has an undesirable effect on agricultural practices. In this work, it was evident that F. chlamydosporum could biodegrade guishe extract components, which would have an impact on its bioactivities. The biotransformation of guishe extract by fermentation with Fusarium chlamydosporum accumulates phytochemical compounds that are considered bioactive. The bioprocessed extracts inhibited phytopathogenic strains, Penicillium sp. and Fusarium sp., with potential use as fungicides in agriculture, as a reduction in mycelium and spore formation was observed. These extracts also had a bioherbicidal effect on Verbesina encelioides plants with good control (ALAM scale) using the BGE-10 treatment, with a visible effect in the reduction of size and color in plant tissue. To our knowledge, the reports from our research group are the only available information on Agave lechuguilla residue (guishe) extract as a biocontrol agent for agricultural applications. This demonstrates that biotransformation can be a biotechnological tool for obtaining phytochemical derivatives with relevant biological activity. By taking into account the results of this work, it would be feasible to develop a biotechnological prototype of biological origin with applications in agriculture for weed management and as a pesticide. Another relevant aspect is that there are low-income rural communities that process Agave lechuguilla for its fiber, and the residual material represents an additional resource for potential agricultural applications.
Author Contributions
Methodology, Writing—original draft, Conceptualization, Resources: J.H.S.-R.; Writing—review and editing, Conceptualization: A.G.R.; Project administration, Resources, Funding acquisition: L.J.R.-G.; Supervision: E.I.L.-A.; Supervision: M.C.-R.; Supervision: R.A.-V.; Supervision: T.K.M.-M.; Conceptualization, Funding acquisition, Project administration, Writing—review and editing: M.A.M.-M. All authors have read and agreed to the published version of the manuscript.
Funding
We would like to thank the National Council of Humanities, Sciences, and Technologies for the awarded grants (CONAHCyT–315846 and CONAHCyT–322622) to our research group, which made possible the execution of this work.
Data Availability Statement
Data will be made available upon request.
Acknowledgments
José Humberto Sánchez Robles would like to thank the National Council of Humanities, Sciences, and Technologies for the scholarship awarded for his postgraduate studies.
Conflicts of Interest
The authors declare no conflicts of interest.
References
- Gupta, V.; Jamwa, G.; Rai, G.K.; Gupta, S.K.; Shukla, R.M.; Dadrwal, B.K.; Prabhakar, P.; Tripathy, S.; Rajpoot, S.K.; Singh, A.K.; et al. Biosynthesis of biomolecules from saffron as an industrial crop and their regulation, with emphasis on the chemistry, extraction methods, identification techniques, and potential applications in human health and food: A critical comprehensive review. Biocatal. Agric. Biotechnol. 2024, 59, 103260. [Google Scholar] [CrossRef]
- Iqbal, M.M.; Nishimura, M.; Tsukamoto, Y.; Yoshizawa, S. Changes in microbial community structure related to biodegradation of eelgrass (Zostera marina). Sci. Total Environ. 2024, 930, 172798. [Google Scholar] [CrossRef]
- Parhizkar, H.; Taddei, P.; Weziak-Bialowolska, D.; Mcneely, E.; Spengler, D.; Guillermo, J.; Laurent, C. Higher-order interactions and emergent properties of microbial communities: The power of synthetic ecology. Heliyon 2023, 10, e33896. [Google Scholar] [CrossRef]
- Dulf, F.V.; Vodnar, D.C.; Toşa, M.I.; Dulf, E.H. Simultaneous enrichment of grape pomace with γ-linolenic acid and carotenoids by solid-state fermentation with Zygomycetes fungi and antioxidant potential of the bioprocessed substrates. Food Chem. 2020, 310, 125927. [Google Scholar] [CrossRef]
- Sidana, J.; Singh, B.; Sharma, O.P. Saponins of agave: Chemistry and bioactivity. Phytochemistry 2016, 130, 22–46. [Google Scholar] [CrossRef]
- Álvarez-Chávez, J.; Villamiel, M.; Santos-Zea, L.; Ramírez-Jiménez, A.K. Agave by-products: An overview of their nutraceutical value, current applications, and processing methods. Polysaccharides 2021, 2, 720–743. [Google Scholar] [CrossRef]
- Díaz-Jiménez, L.; Carlos-Hernández, S.; Jasso de Rodriguez, D.; Rodríguez-García, R. Conceptualization of a biorefinery for guishe revalorization. Ind. Crops Prod. 2019, 138, 111441. [Google Scholar] [CrossRef]
- Morreeuw, Z.; Escobedo-Fregoso, C.; Ríos-González, L.J.; Castillo-Quiroz, D.; Reyes, A.G. Transcriptome-based metabolic profiling of flavonoids in Agave lechuguilla waste biomass. Plant Sci. 2021, 305, 110748. [Google Scholar] [CrossRef]
- Reyna, C.T. Phytochemical Identification and Isolation of Endophytic Microorganisms from Agave Americana; María Auxiliadora University: Lima, Perú, 2019; p. 51. Available online: https://hdl.handle.net/20.500.12970/238 (accessed on 24 February 2025).
- Sánchez Robles, J.H.; Luna Enríquez, C.F.; Reyes, A.G.; Cruz Requena, M.; Ríos González, L.J.; Morales Martínez, T.K.; Ascacio Valdés, J.A.; Medina Morales, M.A. Initial study of fungal bioconversion of guishe (Agave lechuguilla residue) juice for bioherbicide activity on model seeds. Fermentation 2023, 9, 421. [Google Scholar] [CrossRef]
- Wang, Z.F.; Zhang, W.; Xiao, L.; Zhou, Y.M.; Du, F.Y. Characterization and bioactive potentials of secondary metabolites from Fusarium chlamydosporum. Nat. Prod. Res 2020, 34, 889–892. [Google Scholar] [CrossRef]
- Qin, Y.; Li, Q.; Luo, F.; Fu, Y.; He, H. One-step purification of two novel thermotolerant β-1,4-glucosidases from a newly isolated strain of Fusarium chlamydosporum HML278 and their characterization. AMB Express 2020, 10, 182. [Google Scholar] [CrossRef]
- Thomas, T.A.; Tirumale, S. Production of lycopene by Fusarium chlamydosporum and its anti-inflammatory activity on raw macrophage cell line. Appl. Biochem. Microbiol. 2023, 59, 308–315. [Google Scholar] [CrossRef]
- Gupta, V.K.; Kubicek, C.P.; Berrin, J.G.; Wilson, D.W.; Couturier, M.; Berlin, A.; Filho, E.X.F.; Ezeji, T. Fungal enzymes for bio-products from sustainable and waste biomass. Trends Biochem. Sci. 2016, 41, 633–645. [Google Scholar] [CrossRef]
- Xie, P.; Huang, L.; Zhang, C.; Zhang, Y. Phenolic compositions, and antioxidant performance of olive leaf and fruit (Olea europaea L.) extracts and their structure-activity relationships. J. Funct. Foods 2020, 16, 460–471. [Google Scholar] [CrossRef]
- López-Trujillo, J.; Medina-Morales, M.A.; Sánchez-Flores, A.; Arévalo, C.; Ascacio-Valdés, J.A.; Mellado, M.; Aguilar, C.N.; Aguilera-Carbo, A.F. Solid bioprocess of tarbush (Flourensia cernua) leaves for β-glucosidase production by Aspergillus niger: Initial approach to fiber–glycoside interaction for enzyme induction. 3 Biotech 2017, 7, 271. [Google Scholar] [CrossRef]
- Ulrich, A.; Müller, C.; Gasparetto, I.G.; Bonafin, F.; Diering, N.L.; Camargo, A.F.; Reichert Júnior, F.W.; Paudel, S.R.; Treichel, H.; Mossi, A.J. Bioherbicide effects of Trichoderma koningiopsis associated with commercial formulations of glyphosate in weeds and soybean plants. Crop Prot. 2023, 172, 106346. [Google Scholar] [CrossRef]
- Barahudin, N.F.; Osman, N.I. Plant development, stress responses, and secondary metabolism under ethylene regulation. Plant Stress 2023, 7, 100146. [Google Scholar] [CrossRef]
- Silva-Beltrán, N.P.; Ruiz-Cruz, S.; Cira-Chávez, L.A.; Estrada-Alvarado, M.I.; Ornelas-Paz, J.D.; López-Mata, M.A.; Del-Toro-Sánchez, C.L.; Ayala-Zavala, J.F.; Márquez-Ríos, E. Tomatidine contents and antioxidant and antimicrobial activities of extracts of tomato plant. Int. J. Anal. Chem. 2015, 2015, 84071. [Google Scholar] [CrossRef]
- Rossi, Y.E.; Vanden Braber, N.L.; Díaz Vergara, L.I.; Montenegro, M.A. Bioactive ingredients obtained from agro-industrial byproducts: Recent advances and innovation in micro-and nanoencapsulation. J. Agric. Food Chem. 2021, 69, 15066–15075. [Google Scholar] [CrossRef]
- Peña-Rodríguez, A.; Morreeuw, Z.; García-Luján, J.; Rodríguez-Jaramillo, M.C.; Guzmán-Villanueva, L.; Escobedo-Fregoso, C.; Tovar-Ramírez, D.; Reyes, A.G. Evaluation of Agave lechuguilla by-product crude extract as a feed additive for juvenile shrimp Litopenaeus vannamei. Aquac. Res. 2020, 51, 1–10. [Google Scholar] [CrossRef]
- Wong-Paz, J.E.; Contreras-Esquivel, J.C.; Rodríguez-Herrera, R.; Carrillo-Inungaray, M.L.; López, L.I.; Nevárez-Moorillón, V.; Aguilar, C.N. Total phenolic content, in vitro antioxidant activity and chemical composition of plant extracts from semiarid Mexican región. Asian Pac. J. Trop. Med. 2015, 8, 104–111. [Google Scholar] [CrossRef] [PubMed]
- Li, Z.H.; Wang, Q.; Ruan, X.; Pan, C.; Jiang, D.A. Phenolics and plant allelopathy. Molecules 2010, 15, 8933–8952. [Google Scholar] [CrossRef] [PubMed]
- Khadir, M.; Boubaker, H.; Askarne, L.; Farhaoui, A.; Taoussi, M.; Haddou, L.; Cherrate, M.; Ouchari, W.; Zerrouk, M.; Sobeh, M.; et al. Exploration of the antifungal potential of aqueous extracts from two agave species against major postharvest diseases in apples. Postharvest Biol. Technol. 2024, 214, 112992. [Google Scholar] [CrossRef]
- Kuwahara, Y.; Nakajima, D.; Shinpo, S.; Nakamura, M.; Kawano, N.; Kawahara, N.; Yamazaki, M.; Saito, K.; Suzuki, H.; Hirakawa, H. Identification of potential genes involved in triterpenoid saponins biosynthesis in Gleditsia sinensis by transcriptome and metabolome analyses. J. Nat. Med. 2019, 73, 369–380. [Google Scholar] [CrossRef]
- Mushtaq, W.; Ain, Q.; Siddiqui, M.B.; Alharby, H.; Hakeem, K.R. Allelochemicals change macromolecular content of some selected weeds. S. Afr. J. Bot. 2020, 130, 177–184. [Google Scholar] [CrossRef]
- Schumann, U.; Smith, N.A.; Wang, M.B. A fast and efficient method for preparation of high-quality RNA from fungal mycelia. BMC Res. Notes 2013, 6, 71. [Google Scholar] [CrossRef]
- Cervantes-Güicho, V.J.; Reyes, A.G.; Nuncio, A.; Sepúlveda-Torre, L.; Landa-Cansigno, C.; Rodríguez-De la Garza, J.A.; Medina-Morales, M.A.; Ríos-González, L.J.; Morales-Martínez, T.K. Box-Behnken Design for DPPH free radical scavenging activity optimization from microwave-assisted extraction of polyphenolic compounds from Agave lechuguilla Torr. residues. Processes 2024, 12, 2005. [Google Scholar] [CrossRef]
- López Urquídez, G.A.; Murillo-Mendoza, C.A.; Martinez-López, J.A.; Ayala-Tafoya, F.; Yañez-Juárez, M.G.; Lopez-Orona, C.A. Effect of preemergent herbicides on weed control and onion development under fertigation conditions. Rev. Mex. Cienc. Agric. 2020, 11, 1149–1161. [Google Scholar] [CrossRef]
- Ghitti, E.; Rolli, E.; Crotti, E.; Borin, S. Flavonoids are intra- and inter-kingdom modulator signals. Microorganisms 2022, 10, 2479. [Google Scholar] [CrossRef]
- Ran, J.; Su, Y.; Wang, P.; Yang, W.; Li, R.; Jiao, L.; Zhao, R. Effect of Lactobacillus acidophilus fermentation on bioaccessibility: The relationship between biotransformation and antioxidant activity of apple polyphenols based on metabolomics. LWT 2023, 190, 115360. [Google Scholar] [CrossRef]
- Cano-Flores, A. Biotransformation of triterpenes with different microorganisms. Mex. J. Pharm. Sci. 2013, 44, 7–16. Available online: https://www.scielo.org.mx/pdf/rmcf/v44n2/v44n2a2.pdf (accessed on 10 March 2025).
- Jasso De Rodríguez, D.; García, R.R.; Hernández-Castillo, F.D.; Aguilar, C.N.; Sáenz Galindo, A.; Villarreal Quintanilla, J.A.; Moreno Zuccolotto, L.E. In vitro antifungal activity of extracts of Mexican Chihuahuan Desert plants against postharvest fruit fungi. Ind. Crops Prod. 2011, 34, 960–966. [Google Scholar] [CrossRef]
- Redondo-Blanco, S.; Fernández, J.; López-Ibáñez, S.; Miguélez, E.; Villar, C.; Lombó, F. Plant phytochemicals in food preservation: Antifungal bioactivity: A review. J. Food Prot. 2020, 83, 163–171. [Google Scholar] [CrossRef] [PubMed]
- Jasso de Rodríguez, D.; Salas-Méndez, E.J.; Rodríguez-García, R.; Hernández-Castillo, F.D.; Díaz-Jiménez, M.L.V.; Sáenz-Galindo, A.; González-Morales, S.; Flores-López, M.L.; Villarreal-Quintanilla, J.A.; Peña-Ramos, F.M.; et al. Antifungal activity in vitro of ethanol and aqueous extracts of leaves and branches of Flourensia spp. against postharvest fungi. Ind. Crops Prod. 2017, 107, 499–508. [Google Scholar] [CrossRef]
- Álvarez-Pérez, O.B.; Ventura-Sobrevilla, J.M.; Ascacio-Valdés, J.A.; Rojas, R.; Verma, D.K.; Aguilar, C.N. Valorization of Flourensia cernua DC as source of antioxidants and antifungal bioactives. Ind. Crops Prod. 2020, 152, 112422. [Google Scholar] [CrossRef]
- El Khetabi, A.; El Ghadraoui, L.; Ouaabou, R.; Ennahli, S.; Barka, E.A.; Lahlali, R. Antifungal activities of aqueous extracts of moroccan medicinal plants against Monilinia spp. agent of brown rot disease. J. Nat. Pestic. Res. 2023, 5, 100038. [Google Scholar] [CrossRef]
- Chou, C.H. Introduction to allelopathy. In Allelopathy: A Physiological Process with Ecological Implications; Reigosa, M.J., Pedrol, N., Gonzalez, L., Eds.; Springer: Dordrecht, The Netherlands, 2006; pp. 1–9. [Google Scholar] [CrossRef]
- Iqbal, J.; Zaib, S.; Farooq, U.; Khan, A.; Bibi, I.; Suleman, S. Antioxidant, antimicrobial, and free radical scavenging potential of aerial parts of Periploca aphylla and Ricinus communis. Pharmacology 2012, 6, 563267. [Google Scholar] [CrossRef]
- Saadaoui, E.; Martín, J.; Ghazel, N.; Ben Romdhane, C.; Massoudi, N.; Cervantes, E. Allelopathic effects of aqueous extracts of Ricinus communis L. on the germination of six cultivated species. Int. J. Plant Soil Sci. 2015, 7, 220–227. [Google Scholar] [CrossRef]
- Anh, L.; Van Quan, N.; Tuan Nghia, L.; Dang Xuan, T. Phenolic allelochemicals: Achievements, limitations, and prospective approaches in weed management. Weed Biol. Manag. 2021, 21, 37–67. [Google Scholar] [CrossRef]
- Gomaa, N.H.; Hassan, M.O.; Fahmy, G.M.; Gonzalez, L.; Hammouda, O.; Atteya, A.M. Allelopathic effects of Sonchus oleraceus L. on the germination and seedling growth of crop and weed species. Acta Bot. Bras. 2014, 28, 408–416. [Google Scholar] [CrossRef]
- Aburge, S.; Quashie-Sam, S.J.Q. Evaluating the allelopathic effect of Jatropha curcas aqueous extract on germination, radical, and plumule length of crops. Int. J. Agric. Biol. 2010, 12, 769–772. Available online: https://www.cabidigitallibrary.org/doi/pdf/10.5555/20103309369 (accessed on 27 February 2025).
- Basile, A.; Sorbo, S.; Giordano, S.; Ricciardi, L.; Ferrara, S.; Montesano, D.; Ferrara, L. Antibacterial and allelopathic activity of extract from Castanea sativa leaves. Phytotherapy 2000, 71, S110–S116. [Google Scholar] [CrossRef] [PubMed]
- About, M.; Bensellam, E.; Elyacoubi, H.; Moutiq, R.; Rochdi, A. Biocidal allelopathic effects in vitro of aqueous and organic fractions extracts of Visnaga daucoides and Ricinus communis on a noxious weed (Phalaris canariensis) and a cultivated plant (Lactuca sativa) during seed germination and initial seedling growth. Int. J. Chem. Biochem. Sci. 2022, 22, 100–109. Available online: https://www.researchgate.net/publication/369708503_Biocidal_allelopathic_effects_of_aqueous_organic_fractions_extracts_of_Visnaga_daucoides_Ricinus_communis_on_a_noxious_weed_Phalaris_canariensis (accessed on 1 March 2025).
- Davis, S.C.; Ortiz-Cano, H.G. Lessons from the history of Agave: Ecological and cultural context for valuation of CAM. Ann. Bot. 2023, 132, 819–833. [Google Scholar] [CrossRef]
- Hossen, K.; Kato-Noguchi, H. Evaluation of the allelopathic activity of Albizia procera (Roxb.) Benth. as a potential source of bioherbicide to control weeds. Int. J. Plant Biol. 2022, 13, 523–534. [Google Scholar] [CrossRef]
- Cavalcante, B.; Scapini, T.; Camargo, A.; Ulrich, A.; Bonatto, C.; Dalastra, C.; Mossi, A.; Fongaro, C.; Di Piero, R.; Treichel, L. Orange peels and shrimp shell used in a fermentation process to produce an aqueous extract with bioherbicide potential to weed control. Biocatal. Agric. Biotechnol. 2021, 32, 101947. [Google Scholar] [CrossRef]
- Bastos, B.; Deobald, G.; Brun, T.; Prá, V.; Khun, R.; Pinto, A.; Mazutti, M. Solid-state fermentation for production of a bioherbicide from Diaporthe sp. and its formulation to enhance the efficacy. 3 Biotech 2017, 7, 135. [Google Scholar] [CrossRef]
- Schein, D.; Santos, M.S.N.; Schmaltz, S.; Nicola, L.E.P.; Bianchin, C.F.; Ninaus, R.G.; Menezes, B.B.d.; Santos, R.C.d.; Zabot, G.L.; Tres, M.V.; et al. Microbial Prospection for Bioherbicide Production and Evaluation of Methodologies for Maximizing Phytotoxic Activity. Processes 2022, 10, 2001. [Google Scholar] [CrossRef]
- Available online: https://listado.mercadolibre.com.mx/faena-paraquat-glufosinato-herbicida#D[A:faena%20paraquat%20glufosinato%20herbicida] (accessed on 17 June 2025).
Disclaimer/Publisher’s Note: The statements, opinions and data contained in all publications are solely those of the individual author(s) and contributor(s) and not of MDPI and/or the editor(s). MDPI and/or the editor(s) disclaim responsibility for any injury to people or property resulting from any ideas, methods, instructions or products referred to in the content. |
© 2025 by the authors. Licensee MDPI, Basel, Switzerland. This article is an open access article distributed under the terms and conditions of the Creative Commons Attribution (CC BY) license (https://creativecommons.org/licenses/by/4.0/).